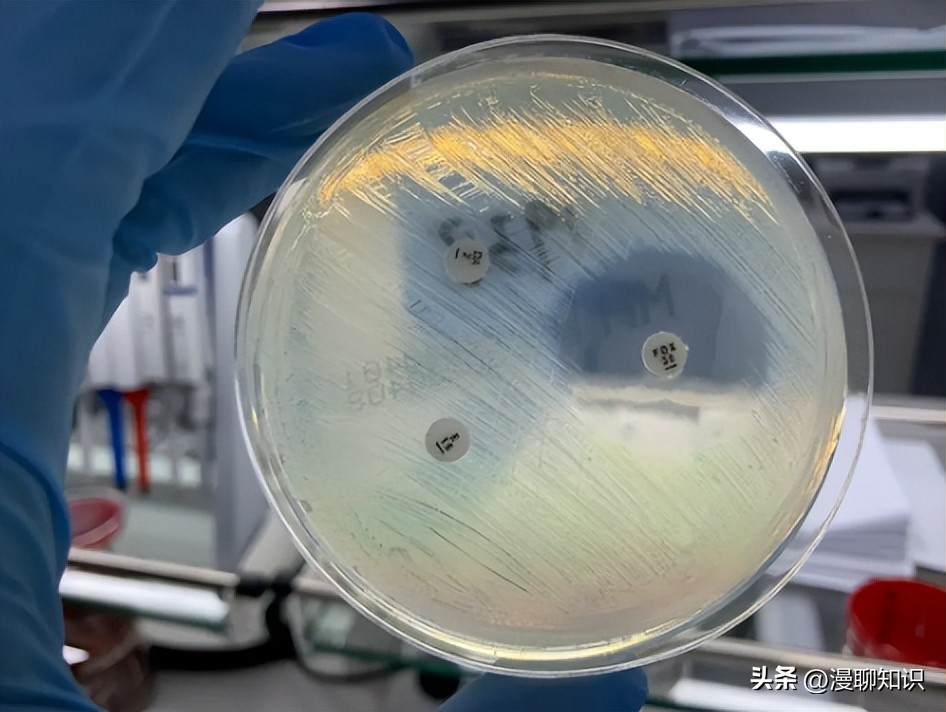
细菌是种类最广泛的畜禽微生物，如何将病毒与之分离
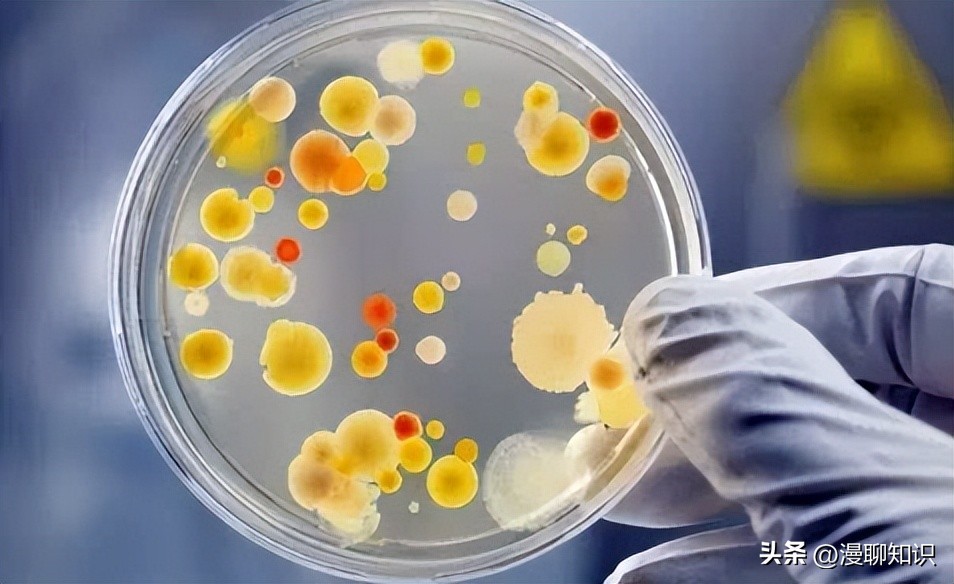
细菌是种类最广泛的畜禽微生物，如何将病毒与之分离
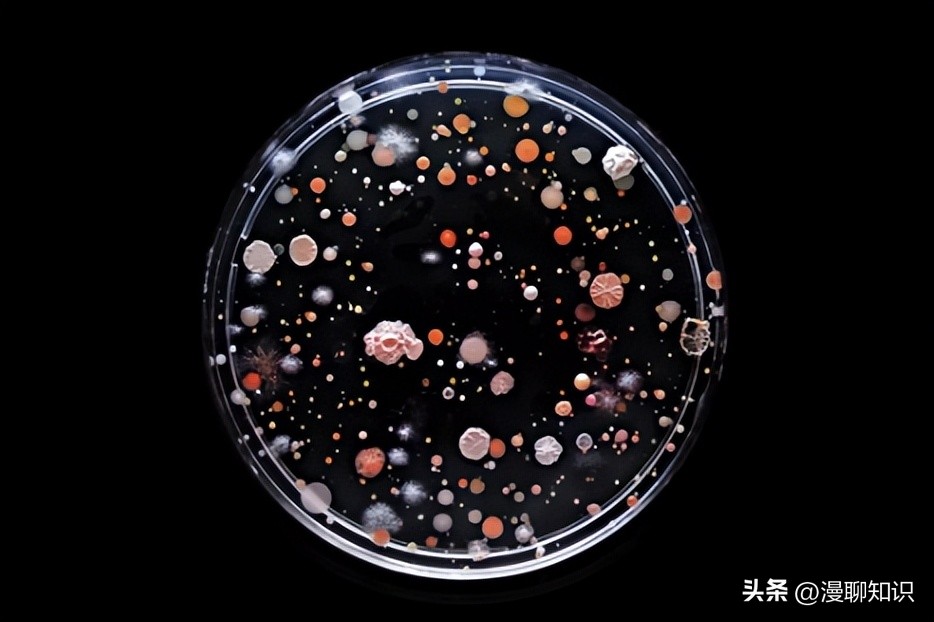
细菌是种类最广泛的畜禽微生物，如何将病毒与之分离

在阅读此文之前,麻烦您点击一下“关注”,既方便您进行讨论与分享,又给您带来不一样的参与感,感谢您的支持!
细菌是种类最广泛、研究得最多的畜禽微生物。
Tan等以猪链球菌为模型,优化了ONT测序和标准化从头组装方法,获得了更高分辨率基因组信息,提供了鉴定猪链球菌基因组序列、序列类型和抗生素耐药谱的方法。
Zhang等用单分子ONT或SMRT技术对猪副嗜血杆菌的基因组进行组装,再用短读长测序技术进行润饰,获得了高质量的基因组,更好地解释了细菌的遗传进化和变异过程。

Lim等用便携式ONT设备从牛肺组织中分离到1株多重耐药菌株和1株泛敏感菌株,分别进行了146和111次测序,从头组装产生了基本完整的非耐药基因组和耐药株基因组。
Kim等用Illumina结合PacBio技术测定了牛分枝杆菌1595的全基因组序列,促进了对分离株毒力和流行病学特征的认识。
Yang等和Han等分别用PacBio平台快速组装了养殖场多耐药性大肠杆菌和金黄色葡萄球菌的全基因组序列,并对重金属耐药基因、抗菌基因和毒力基因进行了分析鉴定。
由于目前大多数测序方法依赖于病毒分离,公开的基因组数量仍然很少,利用单分子测序技术,可以加速对畜禽病毒的了解。
例如,猪伪狂犬病病毒(Pseudorabies virus,PRV)的双链DNA基因组巨大,相对比较复杂,Tombácz等采用长读长和短读长测序相结合的方法对流行株进行全基因组测序,并与其他典型病毒株比较,可跟踪和掌握PRV的分子流行病学变化。
羊痘病毒(CaPVs)毒株在血清学上无法区分,且在基因上高度同源,因此只有通过全基因组测序才能对密切相关的毒株进行分型,Mathijs等利用PacBio、MinION与Illumina相结合的方法,直接从临床样本或商业疫苗批次中生成几乎完整的CaPVs基因组,建立了稳健、经济且广泛适用的山羊痘病毒全基因组测序方案。

禽戊型肝炎病毒(Avian hepatitis E virus,aHEV)在细胞培养中不繁殖,很难对病毒分离株进行完全表征,Asif等[32]利用Nanopore和Illumina技术直接从肝组织中确定了aHEV的全基因组序列,通过比较基因组、系统发育和重组分析揭示了其起源。
D'Andreano等利用Nanopore技术对从患中耳炎狗耳道分离的厚皮马拉色菌(Malassezia pachydermatis)进行全基因组测序和从头组装,为动物和人类健康提供了重要的皮肤病相关基因组信息。

对支原体等非常测生物体,单分子测序技术尚需要进一步完善。
Zhou等用PacBio Sequel单分子测序系统和IonTorrent Personal Genome Machine (PGM)对15株鸭源支原体(Mycoplasma anatis)进行了全基因组测序,获得1个完整基因组和14个基因组草图,系统地鉴定了支原体的毒力相关基因图谱,为未来水禽病原的耐药分子机制、适应性进化、种群结构、疫苗开发、临床快速诊断的遗传标记等研究提供了更多有价值的遗传学基础。

Guo等采用SMRT技术对从1只无症状鸡中分离出的衣原体JX-1菌株进行了全基因组测序,并与相关衣原体进行了比较基因组学分析,从而为遗传多样性提供更多证据。
Berná等使用第三代测序技术对导致牛流产的犬新孢子虫(Neospora caninum)进行了重测序、组装和注释,发现了500多个新基因。
Tayyrov等使用Oxford纳米孔和Illumina法相结合,对犬血管圆线虫(Angiostrongylus vasorum)基因组进行测序。
Gao等将SMRT和Illumina测序相结合研究了艾美耳球虫(Eimeria necatrix)转录组,获得了许多长读长异构体,从中鉴定出一系列lncRNAs、AS事件、APA事件和融合转录本,有助于了解病原虫的发病机制、潜在的药物和疫苗靶点。

因此,结合长读长单分子测序技术获得一些毒力或耐药病原体的全基因组序列,有助于更好地了解畜禽发病机制,发现潜在的药物和耐药靶点,提供抗病新工具或疾病控制策略,同时还可为新型疫苗研制提供信息。
畜禽在生长和繁殖过程中不断受到各种病原体感染的威胁,需要建立快速有效的检测方法。
目前的全面诊断多基于培养和分子联合方法,其中前者需要1~2周,因此如何依靠新技术加速诊断和治疗是努力的方向,而单分子测序技术具有作为快速疾病诊断工具的良好潜力。

畜禽病毒检测和数据分析速度对于传染病爆发十分重要。
利用单分子测序技术可以在更短时间内获得变异病毒基因组,为制定快速准确的遏制和治疗策略提供重要信息。
例如,利用纳米孔技术在犬瘟热流行期间快速完成基因组测序,有助于流行病事件的监测活动,而通过牛BLV基因组的长读长纳米孔测序技术可追踪牛白血病病毒的传播和进化。
Cen等基于Illumina和ONT的全基因组测序技术检测了鹅场中鹅粪和环境样本产NDM(新德里金属酶)的肠道细菌,发现在鹅、无机环境(污水、土壤、饲料和灰尘)和小鼠样本中均有分布,并与不同的抗生素抗药性基因共存。

Freeman等利用Oxford Nanopore技术对患慢性病的牛鼻咽样本进行宏基因组测序,既可节省从采集样品到获得结果的时间,还得到了比培养法更多的牛呼吸系统疾病(BRD)病原体,同时还能鉴定遗传编码的抗性决定因子,并为诊断决策提供信息。
利用单分子测序技术可以获得来源于动物的一些生产化学品的菌株。
Szczerba等利用MinION平台测得了从奶牛瘤胃中分离的新型产气肠杆菌LU2菌株的全基因组序列,分析表明LU2可以通过三羧酸循环还原分支和乙醛酸途径产生琥珀酸,具有成为大量生产琥珀酸的潜力,从而可用来筛选理想性状的化学品菌株,提高动物源化学品生产菌株的利用效率。

乳酸菌是哺乳动物肠道微生物菌群的主要成分,对宿主的健康具有促进作用。
Shi等从健康白羽肉鸡肠道中分离获得罗伊氏乳杆菌S5菌株,并用单分子测序技术测得全基因组图谱,表明为1株优良的益生菌。
利用天然木本植物资源作为动物饲料是一项重要策略。
Du等用SMRT测序技术揭示了青贮饲料微生物共生网络和发酵机理,研究结果表明构树与麸皮组合可以用于制备更高质量的青贮饲料。

奶制品中微生物及其代谢物会显著影响产品风味、溶解性、货架期和安全性。
Zhao等采用SMRT技术对骆驼奶细菌微生物区系进行了研究,共有8 513个分类单元组成,隶属于32个门377个属652个种,表明新鲜骆驼奶具有高度的细菌多样性。
Ma等采用SMRT联合液滴数字PCR技术,对3家奶场的7个山羊奶粉样品进行了细菌污染评价,为奶粉细菌污染的评价提供了一种新方法。

原料奶中的细菌含量和种类影响到乳品质量和安全性。
Liang等将SMRT技术应用于微生物污染鉴别,发现不同地区和季节的原料奶细菌种类具有差异性,且运输距离和时间与卫氏假单胞菌(Pseudomonas weihenstephanensis)的丰度呈正相关,提示该菌含量有望成为评价原料奶新鲜度的依据。
单分子测序技术为动物制品及其原料的质量安全评价和潜在风险控制提供了参考,对促进动物产品行业的健康发展具有重要意义。
肉制品中的物种检测对于防止加工过程中的掺假和污染非常重要。
目前的金标准是实时定量PCR方法,但其靶向能力比较有限,Kissenkötter等利用纳米孔测序技术和离线BLAST搜索数据分析,建立了一个快速测序方案,能在数小时内鉴定出猪肉中掺杂了0.1%的马、鸡、火鸡、牛、羊、鸭、兔、山羊和驴肉,可作为移动式快速检测系统用于现场确定肉制品的污染。
相较于第二代测序技术,以SMRT和ONT为代表的单分子测序技术展现了其独特优势,目前在遗传育种、病原微生物研究、有益微生物开发和产品检测等畜禽科学研究中的应用日益增多。
由于单分子测序技术存在碱基错误率偏高等缺陷,在应用中往往与第二代测序技术等方法相结合,能很好地解决此问题,进一步凸显其优势。
未来,随着机器学习和深度学习等新技术或新方法的融入,以及与其他分子生物学和遗传学技术深入整合应用,有望进一步促进并完善单分子测序技术在畜禽科学中的应用,帮助深入阐明遗传机理、加快选育优良品种、提高检测效率、降低生产成本、辅助精准诊断、促进食品安全,更好地造福人类。